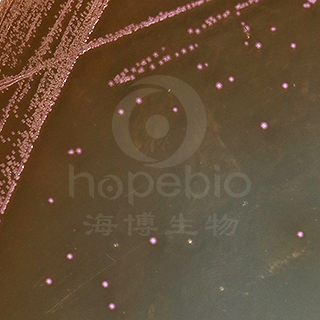
产品细节图片1

万千商家帮你免费找货
0 人在求购买到急需产品
- 详细信息
- 文献和实验
- 技术资料
- 保存条件:
请置于阴凉干燥处保存
- 保质期:
二年
- 英文名:
//
- 库存:
100
- 供应商:
青岛海博生物
- 规格:
1000ml
肠球菌显色培养基是青岛海博生物公司改良的培养基,用于快速检测食品、水质和环境中的肠球菌。菌落显红色至紫色,其它菌显无色、黄色或被抑制。
成份(g/L)
| 营养物质 |
40.1 |
| 吐温80 |
1.0 |
| 显色剂 |
0.25 |
| 琼脂 |
15.0 |
| pH 7.0±0.2 25℃ | |
此配方可以进行改良或增加营养成份以获得最佳的结果。
用法
称取本品 56.4g,水浴加热溶解于 1000ml 蒸馏水中,冷却至 45-50℃ 时,倾入无菌平皿,备用。无需高压灭菌;
操作步骤
使用前,把制备好的培养基放置室温 10-20 分钟。
1、按国家标准、SN标准、FDA标准或其它方法制备样品液;
2、取样品液1ml加入冷却至 45-50℃ 肠球菌显色培养基中混匀或涂布于平板上;或取样品液划线接种于肠球菌显色培养基上;
3、36℃ 培养 24~48h,选用有 30~200 个菌落的平板,计数平板上出现的红色至紫色菌落。
质量控制
1、外观
此干燥培养基的粉末均匀,具有良好的流动性,呈淡黄色至乳白色。制备好的平板呈透明淡黄色培养基。
2、微生物试验
在 36℃ 培养 24-48h:
|
质控菌株 |
ATCC |
生长情况 |
菌落颜色 |
|
单增李斯特氏菌 |
19114 |
- |
/ |
|
金黄se葡萄球菌 |
25923 |
+++ |
黄色 |
|
大肠埃希氏菌 |
25922 |
- |
/ |
|
粪肠球菌 |
19433 |
+++ |
紫色 |
|
屎肠球菌 |
882 |
+++ |
紫色 |
典型特征
典型菌落为红色至紫色。
贮存
制备好的平板应立即使用,应避免光线直接照射。干燥培养基应放置于阴暗干燥处, 保存温度 2-8℃,注意避光保存。
失效
干燥培养基超过保质期、结块和颜色变化都不能使用。
注意
此培养基仅供实验室使用。
|
|
|
|
肠球菌显色培养基 肠球菌 紫红色菌落 |
肠球菌显色培养基 粪肠球菌ATCC29212 紫红色菌落 |
肠球菌显色培养基的微生物灵敏度试验:
按标签用法制备培养基,接种以下质控菌株,放置36±1℃需氧培养24-48小时。
注:回收率计算时,用TSA琼脂做对照培养基。



风险提示:丁香通仅作为第三方平台,为商家信息发布提供平台空间。用户咨询产品时请注意保护个人信息及财产安全,合理判断,谨慎选购商品,商家和用户对交易行为负责。对于医疗器械类产品,请先查证核实企业经营资质和医疗器械产品注册证情况。
文献和实验沙门菌显色培养基CHROMagar与普通培养基SS、HE的比对实验
[摘要] 目的 比对沙门菌显色培养基与普通培养基在检测腹泻便时的敏感性差异。方法 将1000份腹泻便标本增菌后接种沙门菌显色培养基简称(CAS)和SS、HE沙门菌普通培养基做比对试验。结果 沙门菌在CAS平板上呈现特定型的红色菌落,非沙门菌呈现蓝色或无色菌落。1000份腹泻便标本中CAS阳性检出率为1.6%,高于SS阳性检出率1.5%和HE阳性检出率1.4%。结论 采用CAS选择性平板分离沙门菌较易鉴别且直观,同时也可以克服因肉眼挑选带来的主观误差,本次试验
作者:张淑红,吴清平,张菊梅 作者单位:广东环凯微生物科技有限公司,广州510070;2.广东省微生物研究所广东省菌种保藏与应用重点实验室,广州510070 [摘要] 目的:研究显色培养基对单核细胞增生李斯特菌的检测效果,探讨建立新型快速检测方法。方法:检测按国标GB4789—33程序进行。结果:人工污染样品和实际样品检测中,显色培养基CHROMagar Listeria和HKListeria与传统平板OXA和MMA可以达到相同的检测限和灵敏度,且具有更高
(-)、部分有稀疏鞭毛(铅黄肠球菌),Lancefield D 群:大多数菌株产生一种与细胞壁有关的甘油磷壁酸抗原,该抗原被确认为链球菌D 群抗原(80%),适宜温度35-37℃ 大多数细菌在10℃ 和45℃ 生长。 (二)菌落特征BA:灰白色、不透明、表面光滑、直径0.5-1 mm、α-、不溶血、少数β-中国蓝/伊红亚甲蓝/麦康凯/SS:可生长,但菌落较小,发酵乳糖的菌株可形成蓝色或粉红色小菌落。液体培养基:均匀浑浊生长。 (三)生化反应PYR(+) 盲肠肠球菌、哥伦比亚内肠球菌、解糖肠球菌例外LAP
技术资料暂无技术资料 索取技术资料